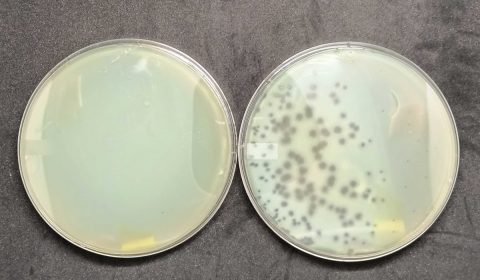

세계적으로 항생제 내성 슈퍼박테리아 문제가 심각해지는 가운데 미국 연구진이 세균에 침투할 수 있는 바이러스인 박테리오파지의 유전자를 조작해 박테리아에 침투시키는 방법으로 치명적인 항생제 내성균을 죽이는 기술을 개발했다.
미국 노스웨스턴대 에리카 하트만 교수팀은 1일 미국 미생물학회(ASM) 학술지 미생물학 스펙트럼(Microbiology Spectrum)에서 박테리아에 박테리오파지 DNA를 투입해 내부로부터 세균을 죽이는 기술을 개발하고, 그 효과를 치명적인 병원균의 하나인 녹농균에서 확인했다고 밝혔다. 연구팀은 박테리오파지를 질병 치료에 이용하는 '파지 치료법'에 대한 관심이 높아지고 있다며 이 연구 결과는 바이러스 DNA를 항생제 내성 박테리아를 죽이는 새로운 치료제로 개발하기 위한 중요한 진전이라고 말했다.
항균제 내성 박테리아 증가는 전 세계 보건에 시급하고 큰 위협이 되고 있다. 미국 질병통제예방센터(CDC)에 따르면 미국에서만 매년 약 300만 건의 슈퍼박테리아 감염이 발생하고 이로 인해 3만5천여 명이 사망하고 있다.
하트만 교수는 "박테리오파지는 여러 면에서 미생물학의 '마지막 미개척지'지만 이를 이용한 파지 치료는 항생제 의존도를 낮출 수 있는 대안으로 떠오르고 있다"고 설명했다. 연구팀은 새로운 파지 치료법 적용 대상으로 인간에게 가장 치명적인 5대 병원균 중 하나인 녹농균을 선택했다. 면역 체계가 약한 사람에게 특히 위험한 녹농균은 병원 감염의 주요 원인으로, 낭포성 섬유증 환자의 폐는 물론 화상이나 수술 환자의 상처에 감염을 일으키기도 한다.
연구팀은 먼저 녹농균 박테리아로 시작해 여러 박테리오파지에서 DNA를 정제하고, 짧은 고전압 펄스를 이용한 전기 천공 기술로 박테리아의 외부 막에 일시적으로 구멍을 낸 다음, 이 구멍으로 정제한 파지 DNA를 주입했다. 그 결과 박테리아 안으로 들어간 파지 DNA는 박테리아의 항바이러스 방어 메커니즘을 무력화시키고 안에서 증식하면서 바이러스 입자인 '비리온'(virion)을 형성했으며 결국 비리온이 세균막을 뚫고 나와 박테리아를 죽이는 것으로 나타났다.
또 자연적으로는 녹농균을 감염시킬 수 없는 두 가지 박테리오파지의 DNA를 추가로 도입한 결과 녹농균에도 강력한 살균 효과를 보이는 것으로 확인됐다. 특히 죽은 박테리아에서 배출된 수십억 개의 박테리오파지는 주변 박테리아들까지 모두 죽이는 것으로 나타났다.
연구팀은 현재 녹농균에서 배출되는 박테리오파지를 연구하고 있으며 앞으로 치료법을 최적화하기 위해 박테리오파지 DNA를 계속 수정할 계획이라고 밝혔다. 하트만 교수는 "파지 치료법이 강력한 점은 항생제와 달리 특정 표적에만 작용한다는 것"이라며 "축농증 치료를 위해 항생제를 복용할 경우 그 영향이 위장관 전체에 미치지만, 파지 치료법은 감염 부위에만 작용하도록 설계할 수 있다"고 말했다.
◆ 출처 : Microbiology Spectrum, Erica Hartmann et al., 'A synthetic biology approach to assemble and reboot clinically relevant Pseudomonas aeruginosa tailed phages', https://doi.org/10.1128/spectrum.02897-23
- 연합뉴스
- 저작권자 2024-02-02 ⓒ ScienceTimes
관련기사

뉴스레터



